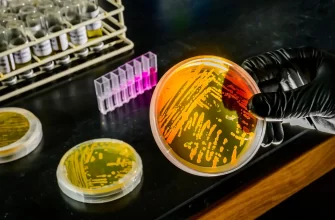

Китайські вчені вперше вилікували діабет 1 типу у 25-річної пацієнтки, яка страждала на хворобу 11 років. Для цього вони використовували стовбурові клітини, отримані з жирової тканини за допомогою хімічного перепрограмування. Уже через 75 днів після трансплантації жінка більше не потребувала інсуліну.

Хімічно індуковані стовбурові клітини створюють за допомогою спеціальних низькомолекулярних хімічних речовин, які діють як фактори перепрограмування. Вони легко виробляються, стандартизуються, не вбудовуються в геном, що дає змогу тонко налаштовувати їхню роботу. Цей метод являє собою новий спосіб отримання плюрипотентних стовбурових клітин для терапії.
Команда під керівництвом Шеня Чжун’яня провела першу в світі успішну пересадку таких клітин пацієнтці, яка страждала на діабет 1 типу 11 років. У минулому вона перенесла дві трансплантації печінки та підшлункової залози, проте попередні операції не принесли довгострокових результатів через ускладнення. Тепер, завдяки стовбуровим клітинам, узятим з її власної жирової тканини та перепрограмованим за методом, розробленим у 2022 році, вдалося досягти стабільного відновлення.
Трансплантат містив клітини, які виробляли інсулін, глюкагон і соматостатин. Процедуру виконали 25 червня 2023 року, ввівши острівцеві клітини в м’язи живота. Через 75 днів пацієнтка повністю відмовилася від інсуліну, а через 4 місяці контроль рівня глюкози в її організмі покращився до 96,21%. Рівень глікованого гемоглобіну, який служить індикатором тривалого контролю над глюкозою, знизився до 5%, що свідчить про повне відновлення. Результати дослідження опубліковані в Nature.
Вчені вважають, що цей метод має величезний потенціал для лікування діабету та інших захворювань. Однак вони підкреслюють, що для його широкого застосування необхідно провести додаткові дослідження, щоб підтвердити безпеку та ефективність пересадки острівцевих клітин, отриманих шляхом хімічної індукції.
#Діабет #типу #вперше #вилікували #повністю #пацієнтам #не #потрібен #інсулін
Source link